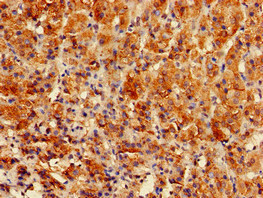

GPAM Antibody
-
中文名稱:GPAM兔多克隆抗體
-
貨號:CSB-PA875724LA01HU
-
規(guī)格:¥440
-
圖片:
-
Immunohistochemistry of paraffin-embedded human endometrial cancer using CSB-PA875724LA01HU at dilution of 1:100
-
Immunohistochemistry of paraffin-embedded human adrenal gland tissue using CSB-PA875724LA01HU at dilution of 1:100
-
Western Blot
Positive WB detected in: Rat heart tissue, Mouse heart tissue
All lanes: GPAM antibody at 3.4μg/ml
Secondary
Goat polyclonal to rabbit IgG at 1/50000 dilution
Predicted band size: 94 kDa
Observed band size: 94 kDa
-
-
其他:
產(chǎn)品詳情
-
產(chǎn)品名稱:Rabbit anti-Homo sapiens (Human) GPAM Polyclonal antibody
-
Uniprot No.:
-
基因名:GPAM
-
別名:Glycerol 3 phosphate acyltransferase 1 mitochondrial antibody; Glycerol 3 phosphate acyltransferase mitochondrial antibody; Glycerol-3-phosphate acyltransferase 1 antibody; Gpam antibody; GPAT antibody; GPAT-1 antibody; GPAT1 antibody; GPAT1_HUMAN antibody; KIAA1560 antibody; MGC26846 antibody; mitochondrial antibody; RP11-426E5.2 antibody
-
宿主:Rabbit
-
反應(yīng)種屬:Human, Mouse, Rat
-
免疫原:Recombinant Human Glycerol-3-phosphate acyltransferase 1, mitochondrial protein (281-459AA)
-
免疫原種屬:Homo sapiens (Human)
-
標(biāo)記方式:Non-conjugated
本頁面中的產(chǎn)品,GPAM Antibody (CSB-PA875724LA01HU),的標(biāo)記方式是Non-conjugated。對于GPAM Antibody,我們還提供其他標(biāo)記。見下表:
-
克隆類型:Polyclonal
-
抗體亞型:IgG
-
純化方式:>95%, Protein G purified
-
濃度:It differs from different batches. Please contact us to confirm it.
-
保存緩沖液:Preservative: 0.03% Proclin 300
Constituents: 50% Glycerol, 0.01M PBS, pH 7.4 -
產(chǎn)品提供形式:Liquid
-
應(yīng)用范圍:ELISA, WB, IHC
-
推薦稀釋比:
Application Recommended Dilution WB 1:200-1:3000 IHC 1:20-1:200 -
Protocols:
-
儲存條件:Upon receipt, store at -20°C or -80°C. Avoid repeated freeze.
-
貨期:Basically, we can dispatch the products out in 1-3 working days after receiving your orders. Delivery time maybe differs from different purchasing way or location, please kindly consult your local distributors for specific delivery time.
-
用途:For Research Use Only. Not for use in diagnostic or therapeutic procedures.
相關(guān)產(chǎn)品
靶點詳情
-
功能:Esterifies acyl-group from acyl-ACP to the sn-1 position of glycerol-3-phosphate, an essential step in glycerolipids biosynthesis such as triglycerides, phosphatidic acids and lysophosphatidic acids.
-
基因功能參考文獻(xiàn):
- High GPAM expression is associated with Ovarian Carcinoma. PMID: 28652252
- two transcriptional initiation sites and two promoters (promoter I and II) required for expression of the human GPAT1 (hGPAT1) gene were identified. PMID: 22634312
- Results suggest that GPAM is expressed in human breast cancer with associated changes in the cellular metabolism, in particular an increased synthesis of phospholipids, the major structural component of cellular membranes. PMID: 22070544
-
亞細(xì)胞定位:Mitochondrion outer membrane; Multi-pass membrane protein.
-
蛋白家族:GPAT/DAPAT family
-
數(shù)據(jù)庫鏈接:
Most popular with customers
-
-
Phospho-YAP1 (S127) Recombinant Monoclonal Antibody
Applications: ELISA, WB, IHC
Species Reactivity: Human
-
-
-
-
-
-